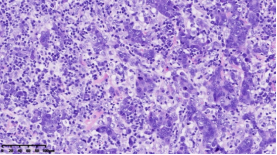

法医学院联合附属肿瘤医院病理科揭示基于组织形态学及IHC的TNBC亚型的临床病理特征及基因变异差异
作为危害全球女性人群健康最常见的恶性肿瘤,乳腺癌的发生、发展是由基因和环境因素联合作用而引起的疾病,是一个多基因、多阶段的变化过程,在全球范围内发病率逐年升高。三阴性乳腺癌(TNBC)是乳腺癌分型中受到广泛关注的一个亚型,是一组高度异质性肿瘤,包含许多不同的具有独特病理学特征和生物学行为的类型,多数为高级别非特殊类型浸润性导管癌。虽然从免疫表型上这些肿瘤均为雌激素受体(ER)、孕激素受体(PR)、人表皮生长因子受体2(HER2)表达阴性,但是每种类型均有不同的组织学形态和生物学行为。TNBC多见于年轻女性,具有高度侵袭性的生物学行为,早期复发及远处转移率较高,无病总生存率较低,预后差,缺乏精准的分型治疗,缺乏明确的靶向治疗,至今仍是非常棘手的问题。目前,寻找TNBC特异性的分子标记物,开展TNBC的分型治疗、靶向治疗成为迫切需要深入研究的主题。
在本项研究中,研究人员利用基本的组织形态学方法及免疫组织化学法对TNBC进行分型:腔面雄激素受体型(LAR)(图1A),免疫调节型(IM)(图1B),基底样免疫抑制型(BLIS)(图1C),间充质型(MES)(图1D)。评价各亚型临床病理参数(如发病年龄、肿物大小、淋巴结转移等),组织形态学(肿物中央瘢痕形成、浸润模式、肿瘤间质浸润淋巴细胞、细胞排列方式、细胞核形态、核分裂计数、间叶化生等)以及免疫表型(p53、Rb、PD-L1、MMR等),结果显示:1.TNBC分型的临床病理、组织形态学和免疫表型特征不尽相同,有望成为复杂的基因表达谱分析的替代选择,为TNBC的分型治疗及靶向治疗提供理论依据;2.生物标记物 PD-L1作为重要的生物学指标,对个体化治疗及免疫治疗有重要的临床指导价值;3.乳腺癌中dMMR作为一个低频发生事件,不太可能作为免疫治疗有效性的评估手段。该成果发表在Virchows Archiv期刊,题目为“Subclassifying Triple-Negative Breast Cancers and Its Potential Clinical Utility”。文章DOI为:10.1007/s00428-022-03329-0。

图1. 基于组织形态学及免疫组织化学标记物的TNBC分型
通过进一步基因表达谱测序,对组织形态学和免疫组化水平界定的TNBC亚型的基因变异情况进行分析,筛选各亚组之间的差异表达基因及表达意义探究,结果显示:1.免疫治疗相关的生物标记物MSI-H、TMB-H,作为一个低频发生事件,在TNBC中不太可能常规作为免疫治疗有效性的评估手段;TNBC的MSI发生机制可能与结直肠癌不同、突变热点不同。2. 整个研究队列中基因表达存在明显差异,充分显示了患者个体间差异的存在,从分子水平揭示了TNBC是一种高度异质性肿瘤。3. TP53基因变异率发生最高,提示在TNBC形成中可能扮演非常重要的角色。4. TNBC分型的基因表达聚类分析方面存在差异(图2),这些差异基因参与了多种不同的生物学通路,筛选特异的分子标记物或靶向治疗的靶点以期指导临床治疗。


图2. 基于组织形态学及免疫组织化学标记物的TNBC亚型的基因表达聚类分析
综上:基于组织形态学及IHC的TNBC分型亚组间的临床病理特征不尽相同,在基因变异聚类方面存在差异,完善了TNBC分型,成为一种实用的、临床可获得的诊断方法,以指导临床病理分型,为TNBC的分型治疗及靶向治疗提供理论依据。
法医学院博士研究生连婧为论文第一作者,法医学院贠克明教授、附属肿瘤医院病理科郗彦凤教授为论文的通讯作者。该项目得到了法医学院、附属肿瘤医院病理科重点实验室的资助。